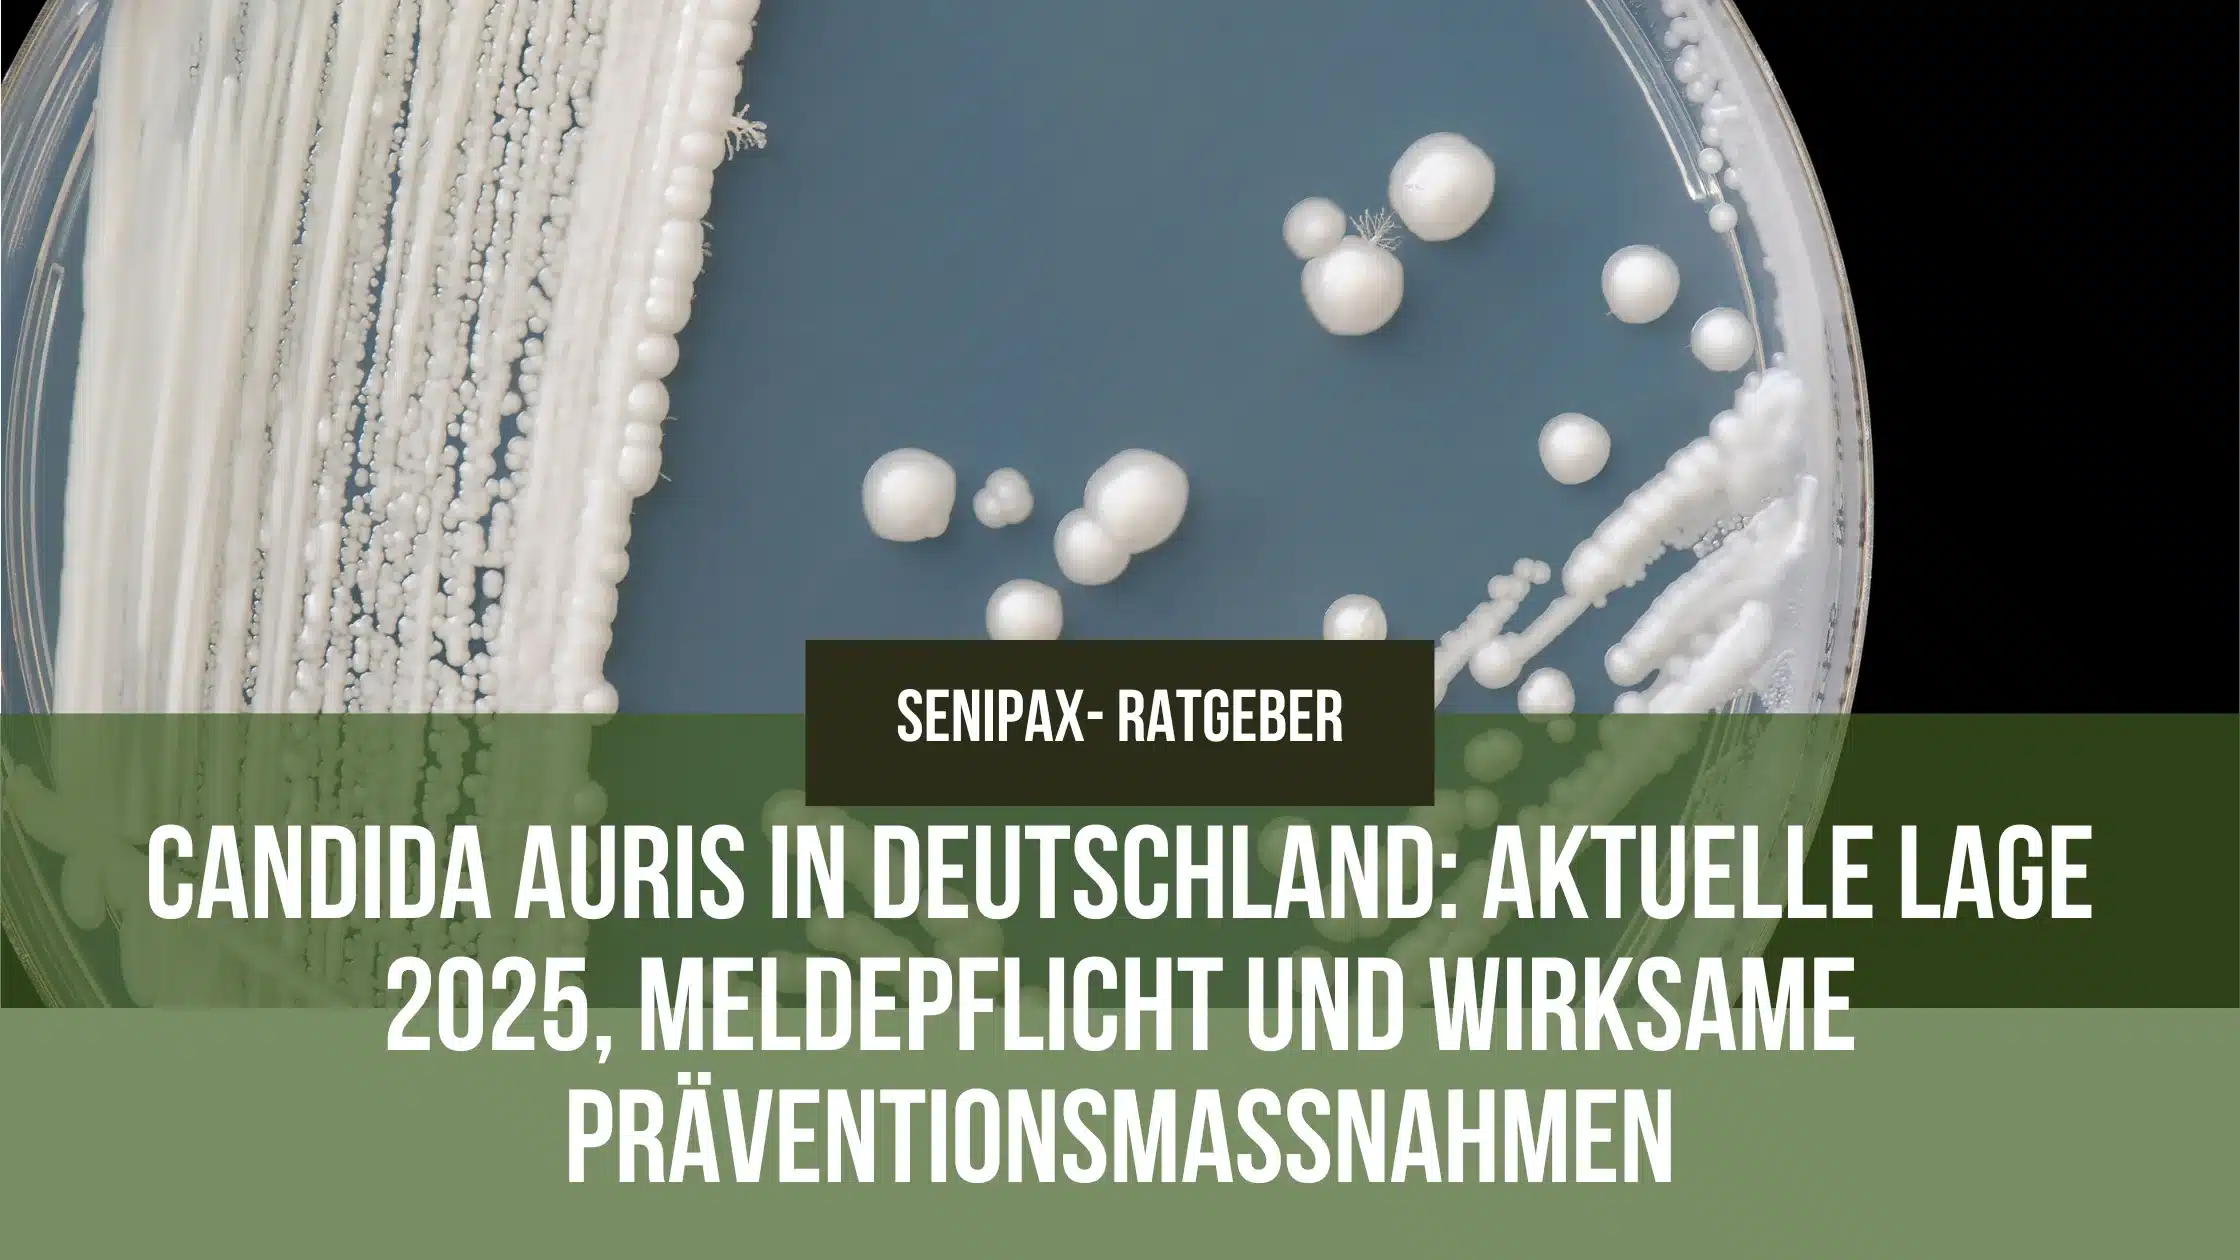

Candida auris in Deutschland: Aktuelle Lage, Meldepflicht und wirksame Präventionsmaßnahmen
Candida auris in Deutschland: Aktuelle Lage 2025, Meldepflicht und wirksame Präventionsmaßnahmen
Kurzfassung: Deutschland meldet auch 2025 weitere invasive Nachweise von Candida auris (syn. Candidozyma auris). Für Einrichtungen sind entscheidend: Händehygiene, sattnasse Wischdesinfektion mit fungiziden/oxidativen Mitteln, validierte Aufbereitung sowie Isolation und Screening. (Stand: 13.09.2025)
Schnellzugriff auf Marken & Sortimente
Direkt zum kompletten Sortiment wechseln – ideal für wiederkehrende Bestellungen.
Aktuelle Lage und Zahlen (Deutschland & EU)
Deutschland 2025 – Meldeweg IfSG (invasive Fälle)
- YTD 2025: Bis Anfang September (KW 36/2025) sind 8 invasive Fälle gemeldet. Verlauf der Jahreskumulativen: KW 11: 3 → KW 19: 5 → KW 22/23: 5 → KW 28: 6 → KW 31: 6 → KW 33: 7 → KW 35–36: 8.
- Vergleich 2024: Im selben Zeitraum lag die Vorjahressumme höher (z. B. KW 36/2024: 14).
- Einordnung: Die IfSG-Meldung erfasst nur invasive Nachweise (Blut/sterile Materialien). Kolonisationen/Screenings laufen primär über Referenz-/Landesstrukturen und Klinik-Hygiene.
Deutschland 2023 – Referenzniveau
- 77 Nachweise (Mehrzahl Kolonisationen); mehrere Ausbrüche dokumentiert.
Europa
- 2013–2023: >4.000 Fälle in EU/EEA; 1.346 Fälle in 2023 (18 Länder). ECDC bewertet das Risiko der weiteren Verbreitung in Krankenhäusern als hoch.
Meldepflicht & rechtlicher Rahmen (Deutschland)
Seit dem 21.07.2023 besteht eine Labormeldepflicht für den direkten Nachweis von C. auris aus Blut bzw. anderen normalerweise sterilen Materialien (IfSG §7 Abs. 1 Nr. 6a). Nosokomiale Ausbrüche sind zusätzlich nach §6 Abs. 3 IfSG meldepflichtig.
Risikoprofil & Übertragungswege
- Persistenz: Lang anhaltende Kolonisation der Haut und Überleben auf Umgebungsflächen (inkl. Biofilmen) begünstigen Transmissionen.
- Resistenzlage: Häufig Azol-Resistenz, zunehmend auch Echinocandin-Resistenzen beschrieben.
- Übertragung: Vorwiegend Kontakt (Hände/Handschuhe, gemeinsam genutzte Medizinprodukte, patientennahe Flächen).
Präventionspaket für Einrichtungen (DE-Kontext)
1) Händehygiene
- Alkoholische Händedesinfektion mit fungizider/levurozider Wirksamkeit einsetzen; vollständige Benetzung und Einreibezeit strikt einhalten.
- Regelmäßige Schulungen, Poster/Audits und Feedback sichern die Compliance.
2) Flächen- und Umfeldhygiene
- Sattnasse Wischdesinfektion patientennaher, häufig berührter Flächen mehrfach täglich und sofort bei Kontamination.
- Mittelwahl: Bevorzugt fungizide (ggf. oxidative) Präparate mit klarer Kontaktzeit. Hinweise deutscher Stellen sprechen gegen den Einsatz rein QAV-basierter Flächendesinfektion bei C. auris, sofern Alternativen verfügbar sind.
- VAH-Listung und Hersteller-Gebrauchsanweisung (IFU) beachten; Materialverträglichkeit prüfen.
Wichtiger Hinweis (VAH/LGL) zur Wirksamkeit
Derzeit ist noch nicht abschließend gesichert, ob das Wirkspektrum der Levurozidie, die die Species Candida albicans einschließt, auch die Wirksamkeit gegen Candida auris abdeckt. Nach Rücksprache mit dem Verbund für angewandte Hygiene e. V. (VAH) ist zum jetzigen Zeitpunkt der Einsatz von Produkten mit ausgewiesener fungizider Wirksamkeit zu empfehlen.
3) Instrumenten- & Endoskopaufbereitung
- Validierte Verfahren (SOP/Gebrauchsanweisung, IFU) und freigegebene Chemikalien nutzen; bei Endoskopen AER-Prozesse gemäß Geräte-/Chemiefreigaben.
- Wo möglich patientenbezogene Geräte; sonst unmittelbare sachgerechte Aufbereitung.
4) Isolation, Screening & Kommunikation
- Einzelzimmerisolation (ggf. Kohortierung) und adäquate PSA bei patientennahen Tätigkeiten.
- Einmalhandschuhe: z. B. Peha-soft® nitrile blue (Nitril, puderfrei, latexfrei) für patientennahe Tätigkeiten; dazu langärmliger Schutzkittel. Bei respiratorischem Nachweis MNS/FFP2 nach Gefährdungsbeurteilung.
- Screening definierter Kontaktpersonen (z. B. Achsel/Leiste, rektal, Wunden) in enger Taktung nach lokalem Hygienekonzept.
- Verlege-Info: C. auris-Status in Arztbrief/Transportunterlagen explizit kommunizieren.
Produktempfehlungen (fungizide Desinfektionslösungen)
Wichtig: Immer Gebrauchsanweisung (IFU) beachten (Wirkspektrum, Einwirkzeit, Materialverträglichkeit). Für Routinezwecke an VAH und die Herstellerangaben orientieren. Bei alkoholsensiblen Materialien geeignete Spezialprodukte wählen.
Empfohlene Produkte (fungizid / gemäß IFU)
Produktvergleich: Fungizide Desinfektionslösungen für die C.-auris-Prävention
Einwirkzeiten/Anwendung immer gemäß Gebrauchsanweisung (IFU) des Herstellers und VAH beachten.
Händedesinfektion (alkoholisch)
| Produkt | Kategorie | Form | Einsatzbereich | Wirkspektrum (Kurz) | Einwirkzeit* | Hinweise |
|---|---|---|---|---|---|---|
| Sterillium® Gel pure | Hände | Gel | Hygienische & chirurgische Händedesinfektion | bakterizid, levurozid/fungizid, begr. viruzid | gemäß IFU | parfüm-/farbstofffrei; hautfreundlich |
| Sterillium® Virugard | Hände | Lösung | Hygienische Händedesinfektion in Hochrisikobereichen | bakterizid, levurozid/fungizid, viruzid | gemäß IFU | für Situationen mit erweitertem Spektrum |
| Sterillium® med | Hände | Lösung | Routinen in Klinik/Pflege, sensitive Haut | bakterizid, levurozid/fungizid, begr. viruzid | gemäß IFU | VAH-gelistet; sehr gute Hautverträglichkeit |
Flächendesinfektion – Schnelldesinfektion & Tücher
| Produkt | Kategorie | Form | Einsatzbereich | Wirkspektrum (Kurz) | Einwirkzeit* | Hinweise |
|---|---|---|---|---|---|---|
| Bacillol® AF 500 ml | Fläche | Flüssig (alkoholisch) | Schnelldesinfektion alkoholbeständiger Oberflächen | bakterizid, levurozid/fungizid, begr. viruzid | gemäß IFU | rückstandsarm; kurze Kontaktzeiten |
| Bacillol® AF Tissues | Fläche | Tücher (alkoholisch) | Point-of-Care, patientennahe Flächen | bakterizid, levurozid/fungizid, begr. viruzid | gemäß IFU | praktisch für Zwischenreinigung |
| Bacillol® Tissues | Fläche | Tücher | Nichtinvasive Medizinprodukte & Oberflächen | levurozid/fungizid (gem. Produkt) | gemäß IFU | schnelle Anwendung ohne Umfüllen |
| Bacillol® Wipes | Fläche | Wipes im Spendersystem | Regelmäßige Wischdesinfektion | levurozid/fungizid (gem. Produkt) | gemäß IFU | komfortabel im Stationsalltag |
| Mikrobac® Virucidal Tissues | Fläche | Tücher (QAV-basiert) | Alkoholsensible Oberflächen/Sonden | levurozid/fungizid (gem. Produkt) | gemäß IFU (z. B. ≥ 5 min) | bei C. auris nur nutzen, wenn fungizid deklariert & Kontaktzeit gesichert |
Flächendesinfektion – Konzentrat (oxidativ)
| Produkt | Kategorie | Form | Einsatzbereich | Wirkspektrum (Kurz) | Einwirkzeit* | Hinweise |
|---|---|---|---|---|---|---|
| Dismozon® Plus | Fläche (Konzentrat) | Oxidativ (z. B. MMPP) | Waschbare Flächen; Routine & Ausbruch | breit; inkl. levurozid/fungizid | gemäß IFU (Konz./Zeit) | Materialverträglichkeit prüfen |
Instrumente & Endoskope
| Produkt | Kategorie | Form | Einsatzbereich | Wirkspektrum (Kurz) | Einwirkzeit* | Hinweise |
|---|---|---|---|---|---|---|
| Korsolex® extra | Instrumente | Konzentrat (aldehydisch) | Thermolabile/-stabile Instrumente | breit; inkl. levurozid/fungizid | gemäß IFU | nur freigegebene Materialien |
| Korsolex® basic | Instrumente | Konzentrat (aldehydisch) | Manuelle Aufbereitung inkl. flex. Endoskope | breit; inkl. levurozid/fungizid | gemäß IFU | Validierungen/SOPs beachten |
| Korsolex® Endo-Disinfectant | Endoskopie | Aufbereitungsmittel | Chem(therm)ische AER-Verfahren | gemäß Freigaben; fungizid | gemäß IFU | nur laut Geräte-/Chemiefreigabe einsetzen |
*Einwirkzeit: Immer Herstellerangaben (Gebrauchsanweisung, IFU) & VAH beachten; korrekte Benetzung („sattnass“) sicherstellen.
Nach Kategorie einkaufen
Alles für Hände, Fläche, Instrumente und Tücher.
Kategorie öffnenVAH-gelistete, hautfreundliche Produkte.
Produkte ansehenSchnelldesinfektion, Tücher & Konzentrate.
Produkte ansehenAlkoholisch & QAV-basiert (mit IFU-Kontaktzeit).
Produkte ansehenAldehydische Medien & kompatible Verfahren.
Produkte ansehenRückstandsarme Lösungen für den POC.
Produkte ansehenFAQ: Candida auris in Deutschland (Stand: 13.09.2025)
Hinweis: Diese Informationen ersetzen keine medizinische Beratung. Orientierung an lokalen Hygieneplänen, VAH und Hersteller-IFU.
Was ist Candida auris und warum ist der Erreger 2025 relevant?
Candida auris ist ein häufig multiresistenter Hefepilz, der vor allem in Kliniken und Pflegeeinrichtungen auftritt. Er kann Patient:innen über lange Zeit kolonisieren, auf Flächen überdauern und in Ausbrüchen auftreten. Behörden stufen das Risiko weiterer Verbreitung als hoch ein.
Wie viele Fälle gibt es aktuell in Deutschland?
Die IfSG-Meldungen erfassen nur invasive Nachweise (Blut/sterile Materialien). Stand KW 36/2025: 8 invasive Fälle kumulativ. Kolonisationen und ausbruchsbezogene Nachweise werden zusätzlich lokal bzw. über Referenzstrukturen erfasst.
Ist Candida auris meldepflichtig?
Ja. Der direkte Nachweis aus Blut oder anderen normalerweise sterilen Materialien ist seit 21.07.2023 labormeldepflichtig (IfSG § 7 Abs. 1 Nr. 6a). Nosokomiale Ausbrüche sind nach § 6 Abs. 3 IfSG zu melden.
Wie wird Candida auris übertragen?
Vorwiegend durch direkten/indirekten Kontakt: Hände/Handschuhe, gemeinsam genutzte Medizinprodukte und patientennahe Flächen. Persistenz auf Haut und Oberflächen (inkl. Biofilmen) begünstigt die Weitergabe.
Welche Desinfektionsmittel sind geeignet?
Bevorzuge fungizid/levurozid ausgewiesene Produkte und beachte die Kontaktzeit. Beispiele: Hände – Sterillium Gel pure, Sterillium Virugard, Sterillium med. Flächen – Bacillol AF 500 ml, Bacillol AF Tissues, Bacillol Tissues, Bacillol Wipes; für alkoholsensible Oberflächen ggf. Mikrobac Virucidal Tissues mit gesicherter fungizider Kontaktzeit. Konzentrat – Dismozon Plus. Instrumente/Endoskope – Korsolex extra, Korsolex basic, Korsolex Endo-Disinfectant.
Wie oft sollte ich Flächen reinigen und desinfizieren?
Mehrfach täglich sattnass wischen in patientennahen Bereichen und immer sofort nach Kontamination. Geeignete fungizide/oxidative Mittel anwenden, Materialverträglichkeit prüfen.
Wie lange isolieren und welche PSA nutzen?
Einzelzimmerisolation (ggf. Kohortierung), PSA bei patientennahen Tätigkeiten (Handschuhe, Schutzkittel). Aufhebung der Isolation nach lokalem Hygienekonzept, oft erst nach wiederholt negativen Abstrichen.
Wer sollte gescreent werden?
Kontaktpersonen (z. B. Zimmernachbar:innen, gemeinsam genutzte Gerätebereiche) gemäß lokalem Konzept; Abstriche typischerweise an Achsel/Leiste, ggf. rektal/Wunden. Wiederholte Testungen bis negative Serien vorliegen.
Was ist bei Verlegung/Transport zu beachten?
C. auris-Status im Arztbrief und in Transportdokumenten explizit ausweisen. Aufnehmende Bereiche frühzeitig informieren, damit Schutzmaßnahmen ohne Verzögerung greifen.
Gibt es eine sichere „Dekolonisation“?
Eine standardisierte Eradikationsstrategie ist nicht etabliert. Der Fokus liegt auf Basishygiene, konsequenter Händehygiene, Flächendesinfektion, Isolation/Screening und strukturierter Aufbereitung.
Quellen / Einzelnachweise
- Robert Koch-Institut (RKI) & NRZ für Mykosen (NRZMyk): Zunahme von Candida auris in Deutschland im Jahr 2023. Epidemiologisches Bulletin 18/2024: 3–7. DOI: 10.25646/12004. (Abgerufen am 13.09.2025)
- RKI: Epidemiologisches Bulletin 2025 – Wochentabellen „Weitere ausgewählte meldepflichtige Infektionskrankheiten“ (Ausgaben 12/13, 19/2025, 22–23/2025, 28/2025, 31/2025, 33/2025, 35/2025, 36/2025) – Zeile „Candida auris, invasive Infektion“. (Abgerufen am 13.09.2025)
- European Centre for Disease Prevention and Control (ECDC): Survey on the epidemiological situation, laboratory capacity and preparedness for Candidozyma/Candida auris, 2024. Veröffentlichung 11.09.2025. (Abgerufen am 13.09.2025)
- Landesamt für Gesundheit und Lebensmittelsicherheit (LGL) Bayern: Merkblatt Candida auris für Krankenhäuser, Stand 12.02.2024 – inkl. Hinweis „Levurozidie deckt C. auris evtl. nicht ab; fungizide Produkte empfohlen (VAH-Rücksprache)“, QAV-Hinweis, PSA (Kittel/Handschuhe), Screening & Isolation. (Abgerufen am 13.09.2025)
- Infektionsschutzgesetz (IfSG): §7 Abs. 1 Nr. 6a (Labormeldepflicht für Candida auris) und §6 Abs. 3 (Meldepflicht Ausbrüche). Amtliche Konsolidierungen. (Abgerufen am 13.09.2025)
- NRZMyk (Jena): Meldepflicht für Candida auris – Hinweis vom 24.07.2023. (Abgerufen am 13.09.2025)
Hinweis: Produktnennungen dienen der Orientierung in Klinik/Pflege. Anwendung ausschließlich gemäß Gebrauchsanweisung (IFU), VAH-Listung und lokalen Hygieneplänen.
